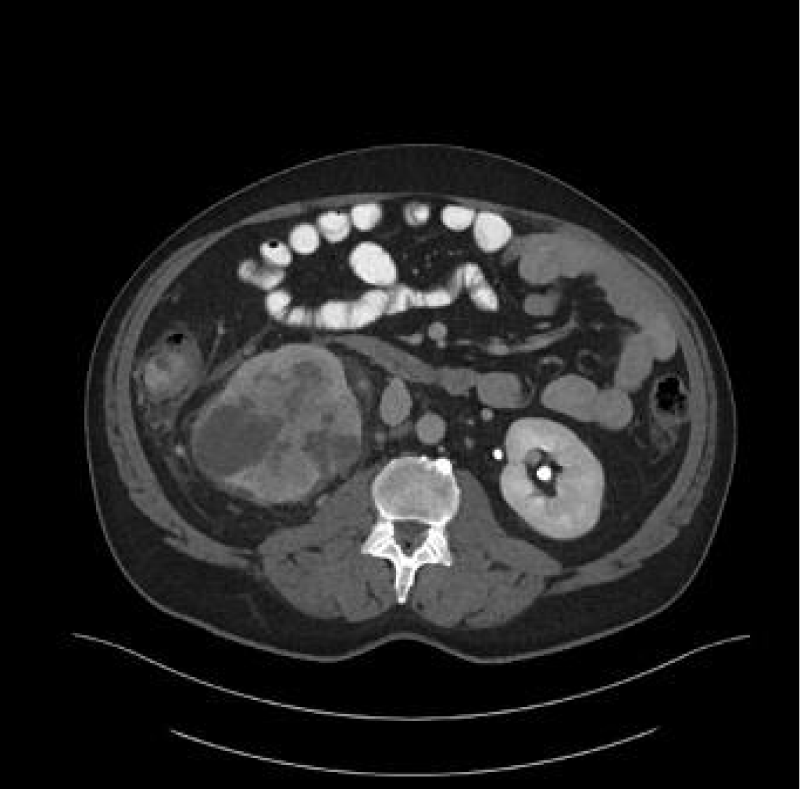
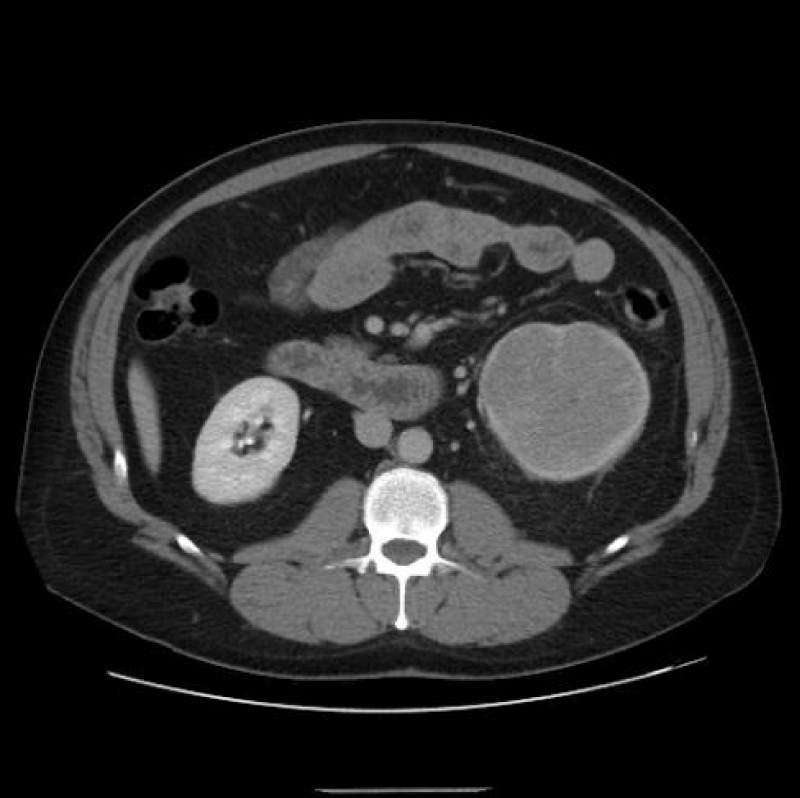

More Information
Submitted: October 26, 2022 | Approved: November 07, 2022 | Published: November 08, 2022
How to cite this article: Idrees H, Zarrar R, Mujtaba B. Renal neoplasms and computed tomography. J Radiol Oncol. 2022; 6: 022-026.
DOI: 10.29328/journal.jro.1001043
Copyright License: © 2022 Idrees H, et al This is an open access article distributed under the Creative Commons Attribution License, which permits unrestricted use, distribution, and reproduction in any medium, provided the original work is properly cited.
Renal neoplasms and computed tomography
Hajra Idrees, MBBS1*, Raza Zarrar, MBBS, MD2 and Bilal Mujtaba, MD1
1Department of Radiology, University of Texas MD Anderson Cancer Center, Houston, Tx, USA
2Department of Internal Medicine, Baptist Hospitals of Southeast Texas, Beaumont, Tx, USA
*Address for Correspondence: Hajra Idrees, MBBS, Department of Radiology, University of Texas MD Anderson Cancer Center, Houston, Tx, USA, Email: [email protected]
Introduction: In recent years the increased utilization of imaging modalities has led to an accelerated diagnosis of renal masses. Initial diagnoses and staging are commonly done with the abdominal Computed Tomography (CT). This study evaluates the various aspects to consider when utilizing CT scan for the diagnosis of renal masses.
Discussion: CT scan is the most important imaging modality to evaluate renal neoplasms. Postcontrast acquisitions can be tailored according to the indication for the study. This alongside various techniques, imaging modalities and classification systems may help differentiate the malignant Renal Cell Carcinoma, from benign or metastatic lesions, lymphomas or renal pseudotumor. Finally CT can also be utilized alongside other tools for staging the tumor.
Conclusion: Certain CT imaging features are pertinent to evaluate the malignancy potential of renal lesions. However the CT alone may be inconclusive in diagnosing the majority of renal neoplasms, excluding AML with macroscopic fat. Hence it is recommended that the CT aid additional imaging modalities and tools to reach an accurate diagnosis.
In recent years the increased utilization of imaging modalities has led to an accelerated amount of renal masses being diagnosed. Commonly an incidental finding on abdominal imaging, these lesions may be benign or malignant. Many of these masses occur as Small Renal Masses (SRM), which are suspicious for malignancy if under 4 cm in the largest dimension on high-quality, multiphase, cross-sectional abdominal imaging with and without contrast enhancement. In the United States, renal cancer is amongst the ten most common tumors; hence imaging is key to identifying their malignant nature to guide further management [1-4].
Initial diagnoses and staging are most commonly done with abdominal Computed Tomography (CT), Magnetic Resonance Imaging (MRI) (Figure 1) and Ultrasound (US) are also frequently used. This is due to CT’s ability to detect up to 90% renal masses including SRM, and its higher spatial resolution compared to the MRI. CT can distinguish benign from malignant lesions hence avoiding further testing and detecting surrounding lymphadenopathy or thrombi (Figure 2), has rapid image acquisition rates, is compatible with metallic medical devices, and can obtain high-resolution enhancement measurements using the Hounsfield unit (HU [1-3,5].
Figure 1: T2 Weighted MRI of a multi-Cystic right renal mass.
Figure 2: Right renal Clear Cell RCC with right Renal Vein thrombus.
The Hounsfield unit scale is used to measure the density or attenuation of a tissue, ranging from low to high. Benign Renal Angiomyolipomas (AML) are fat-containing lesions with low attenuations of –100 to –10 HU. Homogenous masses with low attenuation of -10 to +20HU are usually benign fluid-filled simple cysts. Heterogenous, septated, or calcified entities with attenuation greater than 20 HU, may be malignant and require further testing. Patients with contraindications to CT, or requiring further imaging, may undergo MRI with and without contrast [2,5].
CT technique
CT scan is the most important imaging modality to evaluate renal neoplasms. A contrast-enhanced Multidetector CT (MDCT) is preferred, where a triple-phase helical CT scan is utilized for thin collimation and a superior spatial and temporal resolution. Opacification of the alimentary tract may help distinguish bowels from lymph nodes. The dedicated protocol constitutes an initial ‘pre-contrast’ phase, followed by intravenous (IV) contrast administration. The ‘Corticomedullary’ (CM) phase is seen 25-30 seconds post-contrast, followed by the ‘Nephrogenic Phase’ (NP) seen 70 seconds to 180 seconds later. Eventually, after 7 minutes to 10 minutes the ‘Excretory Phase’ images may be retrieved. Either of the above-mentioned postcontrast acquisitions can be obtained tailored according to the indication for the study, although with the added increased radiation dosage risk [1,2,5,6].
Postcontrast CT acquisition determines lesion size, shape, border, and enhancement. The CM is important to visualize vascular anatomy and early enhancing tumors e.g. Renal Cell Carcinoma (RCC), alongside acute hemorrhagic complications, post-surgery and presurgical planning. NP helps identify renal lesions, assess their enhancement, and highlight small hypo-vascular hypo-attenuated lesions concealed during the CM phase. Whereas the ‘Excretory’ and CM phases may be utilized to subtype RCC, differentiate RCC from urothelial cancer, or assess for a collecting system tumor or opacity e.g. strictures, dilation and leakage. Opacities may be evaluated in two ways. Either ‘Excretory phase’ imaging may be obtained; alternately IV contrast preload may be administered to the patient during the ‘NP’ [1,5,6].
For evaluating SRM (Figure 3), thin CT slices of 2 mm to 3 mm are preferred to demonstrate lesion extent, hence minimizing ‘partial volume artifacts.’ This allows in both the coronal and sagittal planes, post-processing high-resolution Three-Dimensional multiplanar reconstructions (MPR). Maximum intensity projection (MIP) imaging processing tool projects the voxels of the highest attenuation into a Two-Dimensional image. This is especially useful post-operatively, where cortical profiles and the integrity of blood vessels may be evaluated [1,6].
Figure 3: Right renal mass measuring 2 cm.
Despite the array of numerous benefits offered by the increased availability of the CT scan, for some it may come at a heavy price. The side effect profile of CT include the following. Firstly, Radiation induced cancer has been observed in patients exposed to the CT. An increased occurrence of leukemia, brain and other solid carcinomas in the radiation exposed pediatric population has been partially curbed by various measures. These include decreasing the dosage and optimizing CT scan settings [7]. Secondly, while postcontrast acquisitions help better visualize certain renal neoplasms, this does come with the added increased radiation dosage risk. Hence physicians should ensure the benefits of the study outweigh the risks [1,2,5,6]. Thirdly, prescribing physicians should be vigilant of CT IV contrast resulting in Contrast Induced Nephropathy, defined as acute renal failure occurring within 24 to 72 hours of exposure to intravascular radiographic contrast media that cannot be attributed to other causes, with up to 10% patients displaying permanent severe renal failure [8].
Types of renal neoplasms
Renal cell carcinoma (RCC) is the ninth and fourteenth most common carcinoma in men and women respectively, alongside being the most lethal urological malignancy. RCC accounts for up to 90% of all kidney cancers, and up to 80% of all SRM. RCC constitutes Clear Cell (Figures 4-6), 75%, Papillary, around 15% to 20%, Chromophobe (Figures 7-9), 5% and other rarer subtypes. Clear Cell is the most common variant with the worst prognosis as it commonly presents at an advanced stage. Papillary type is more frequent in smaller lesion sizes [1,2,3,9-15].
Figure 4: Clear Cell RCC of the upper pole of the right kidney.
Figure 5: Left renal Clear Cell RCC.
Figure 6: Right renal Clear Cell RCC.
Figure 7: Right renal Chromophobe RCC of the lower pole, with solid and cystic components.
Figure 8: Chromophobe RCC of the lower pole of left kidney.
Figure 9: Chromophobe RCC of the lower pole of right kidney.
Benign Renal tumors constitute Oncocytoma 75%, Renal Angiomyolipoma (AML) 11% and Metanephric Adenoma 3%. Benign lesions may present as suspicious appearing masses and are more frequent amongst females, and in SRM. Around 20% of tumors with diameters from 1 cm and 4 cm are benign, increasing to 40% in tumors under 1 cm. Oncocytoma presents as homogeneous, circumscribed solid masses, with a central scar on CT. This central scar also may be seen in RCC. AML present as an enhancing, macroscopic fat-containing mass devoid of calcifications, whereas Clear Cell RCC occasionally mimics AML but with microscopic fat, hence ‘fat poor’ small AML with little fat requires further evaluation. Tuberous Sclerosis patients may present with bilateral renal AML and an increased risk of RCC, therefore screening for RCC is important in this population. Additionally screening for AML hemorrhage, a common complication is also recommended. Finally, the rare Metanephric Adenomas occur more commonly in females, with approximately 90% containing a BRAF V600 mutation [1,3,16-22].
Renal Metastatic disease typically presents as multiple borderline-enhancing lesions. In patients with non-renal tumors presenting with a solitary renal lesion, there may be two causes. Either a non-renal primary tumor may have metastasized to the kidney. Alternatively, it could be renal cancer in origin. This is usually followed by a biopsy [3,23].
Lymphoma: 34% of terminal lymphoma or leukemia patients are seen to have renal involvement. Renal clinical presentation is commonly delayed or silent. Retroperitoneal lymphadenopathy, splenomegaly, or lymphadenopathy in any body part should prompt suspicion. Percutaneous biopsy is generally diagnostic [3,24].
Renal Pseudotumor Focal hypertrophy of the renal parenchyma, focal pyelonephritis, acute renal infarcts, renal pseudoaneurysms, etc. may occasionally mimic a renal neoplasm on CT. Detailed clinical history and various imaging techniques may help differentiate the entities [1].
Imaging features
Fat on CT is rarer than water or soft tissue i.e. -10 HU. AML presents with less than -20 HU, macroscopic fat, and no calcifications. Rarely 1% of Renal AML may present as ‘lipid poor’ and hence require distinguishing from RCC. Uncommonly ‘fat-containing’ RCC, and ablated renal tumors can mimic Renal AML [1,3,25].
CT Enhancement is an increase in signal greater than 20 HU when compared to its corresponding non-contrast image. It correlates to an increased likelihood of malignancy, classically seen in clear cell RCC. This may not hold for certain lesions, notably the hypovascular papillary RCC. Benign lesions display an attenuation of less than 10 HU and are considered ‘non-enhancing’. A change between 10 and 20 HU is equivocal. Radiologists should be aware of oncocytomas occasionally mimicking clear cell RCC enhancement patterns, and ‘pseudo-enhancement’ of cysts against an avidly enhanced background renal parenchyma. Masses under 1.5 cm in diameter may be difficult to assess for enhancement, here MRI or DECT may be considered [1,3,26,27].
The Bosniak classification system of renal cystic masses utilizes the contrast-enhanced CT depiction of cysts to predict the risk of malignancy. These lesions are then categorized into five groups i.e. either benign (type I and II), likely benign (type IIF), or likely malignant (type III and IV). Simple cyst features distinguishing cysts from tumors or abscesses on the US constitute, round sharp smooth walls, ‘anechoic’ absent echoes in the cyst, (Figures 10 a,b) and a strong posterior wall echo, indicating adequate transmission. When these three criteria are not satisfied, CT is indicated [1-3,5,28-30].
Figure 10a,b: Right cystic mass now with solid components concerning renal neoplasm with increased vascularity.
Tumor complexity illustrates the size of the lesion and its distance from the renal hilum. The RENAL Nephrometry score, the Padua Prediction Score and the C-index, etc. evaluate this complexity as either ‘low’ or ‘high’ to guide management [3,31-33].
Staging
Abdominal CT is the preferred modality for staging the locoregional tumor and thus pre-operative planning, while both MRI and CT are utilized to evaluate distant metastases. CT angiographic techniques help identify feeding arteries, and vascular invasion, and aid in preoperative planning by evaluating tumor distance from the renal hilum and collecting system on acquisitions. A study determined the accuracy of CT detection of renal vein invasion, metastatic adenopathy, perinephric invasion and neighboring organ spread as, 78% sensitive and 96% specific, 83% sensitive and 88% specific, only 46% sensitive and 98% specific and 100% specific, respectively. Occasionally CT falls short of other imaging modalities. Despite the CT ‘size criteria’ for evaluating nodal metastasis, a normal size lymph node with metastasis may go undetected. Additionally, CT may be unable to detect many renal vein or perinephric invasions, resulting in upstaging in patients undergoing nephrectomy. Here, MRI is superior in differentiating between stages T2 and T3a, as well as T3 and T4. Additionally, MRI is also preferred for Renal Vein and Inferior Vena Cava malignant thrombi detection, TNM staging of tumor outside the renal capsule or Gerota’s fascia and detecting the cranial extent of the venous thrombus [3,5,34-36].
Summary
In conclusion, certain CT features are key in gauging renal masses and their likelihood of malignancy. Except for AML with macroscopic fat, diagnosing kidney neoplasms with the CT alone is commonly inadequate, and should be used in conjunction with other imaging modalities and diagnostic tools.
- Wang ZJ, Westphalen AC, Zagoria RJ. CT and MRI of small renal masses. Br J Radiol. 2018 Jul;91(1087):20180131. doi: 10.1259/bjr.20180131. Epub 2018 May 10. PMID: 29668296; PMCID: PMC6221773.
- Gray RE, Harris GT. Renal Cell Carcinoma: Diagnosis and Management. Am Fam Physician. 2019 Feb 1;99(3):179-184. Erratum in: Am Fam Physician. 2019 Jun 15;99(12):732. PMID: 30702258.
- Diagnostic approach, differential diagnosis, and management of a small renal mass. https://www.uptodate.com/contents/diagnostic-approach-differential-diagnosis-and-management-of-a-small-renal-mass?search=RENAL%20MASSES%20TYPES&source=search_result&selectedTitle=1~150&usage_type=default&display_rank=1
- Campbell S, Uzzo RG, Allaf ME, Bass EB, Cadeddu JA, Chang A, Clark PE, Davis BJ, Derweesh IH, Giambarresi L, Gervais DA, Hu SL, Lane BR, Leibovich BC, Pierorazio PM. Renal Mass and Localized Renal Cancer: AUA Guideline. J Urol. 2017 Sep;198(3):520-529. doi: 10.1016/j.juro.2017.04.100. Epub 2017 May 4. PMID: 28479239.
- Kang SK, Kim D, Chandarana H. Contemporary imaging of the renal mass. Curr Urol Rep. 2011 Feb;12(1):11-7. doi: 10.1007/s11934-010-0148-y. PMID: 20949339.
- Comai A, Trenti M, Mayr R, Pycha A, Bonatti G, Lodde M. Computed tomography after nephron-sparing surgery. Abdom Imaging. 2015 Oct;40(7):2424-31. doi: 10.1007/s00261-015-0410-3. PMID: 25820803.
- Kutanzi KR, Lumen A, Koturbash I, Miousse IR. Pediatric Exposures to Ionizing Radiation: Carcinogenic Considerations. Int J Environ Res Public Health. 2016 Oct 28;13(11):1057. doi: 10.3390/ijerph13111057. PMID: 27801855; PMCID: PMC5129267.
- Andreucci M, Solomon R, Tasanarong A. Side effects of radiographic contrast media: pathogenesis, risk factors, and prevention. Biomed Res Int. 2014;2014:741018. doi: 10.1155/2014/741018. Epub 2014 May 11. PMID: 24895606; PMCID: PMC4034507.
- Rossi SH, Klatte T, Usher-Smith J, Stewart GD. Epidemiology and screening for renal cancer. World J Urol. 2018 Sep;36(9):1341-1353. doi: 10.1007/s00345-018-2286-7. Epub 2018 Apr 2. PMID: 29610964; PMCID: PMC6105141.
- Pierorazio PM, Patel HD, Johnson MH, Sozio SM, Sharma R, Iyoha E, Bass EB, Allaf ME. Distinguishing malignant and benign renal masses with composite models and nomograms: A systematic review and meta-analysis of clinically localized renal masses suspicious for malignancy. Cancer. 2016 Nov 15;122(21):3267-3276. doi: 10.1002/cncr.30268. Epub 2016 Aug 10. PMID: 27508947.
- Frank I, Blute ML, Cheville JC, Lohse CM, Weaver AL, Zincke H. Solid renal tumors: an analysis of pathological features related to tumor size. J Urol. 2003 Dec;170(6 Pt 1):2217-20. doi: 10.1097/01.ju.0000095475.12515.5e. PMID: 14634382.
- Srigley JR, Delahunt B, Eble JN, Egevad L, Epstein JI, Grignon D, Hes O, Moch H, Montironi R, Tickoo SK, Zhou M, Argani P; ISUP Renal Tumor Panel. The International Society of Urological Pathology (ISUP) Vancouver Classification of Renal Neoplasia. Am J Surg Pathol. 2013 Oct;37(10):1469-89. doi: 10.1097/PAS.0b013e318299f2d1. PMID: 24025519.
- Thompson RH, Hill JR, Babayev Y, Cronin A, Kaag M, Kundu S, Bernstein M, Coleman J, Dalbagni G, Touijer K, Russo P. Metastatic renal cell carcinoma risk according to tumor size. J Urol. 2009 Jul;182(1):41-5. doi: 10.1016/j.juro.2009.02.128. Epub 2009 May 17. PMID: 19450840; PMCID: PMC2735023.
- Jewett MA, Mattar K, Basiuk J, Morash CG, Pautler SE, Siemens DR, Tanguay S, Rendon RA, Gleave ME, Drachenberg DE, Chow R, Chung H, Chin JL, Fleshner NE, Evans AJ, Gallie BL, Haider MA, Kachura JR, Kurban G, Fernandes K, Finelli A. Active surveillance of small renal masses: progression patterns of early stage kidney cancer. Eur Urol. 2011 Jul;60(1):39-44. doi: 10.1016/j.eururo.2011.03.030. Epub 2011 Apr 1. PMID: 21477920.
- Pierorazio PM, Johnson MH, Ball MW, Gorin MA, Trock BJ, Chang P, Wagner AA, McKiernan JM, Allaf ME. Five-year analysis of a multi-institutional prospective clinical trial of delayed intervention and surveillance for small renal masses: the DISSRM registry. Eur Urol. 2015 Sep;68(3):408-15. doi: 10.1016/j.eururo.2015.02.001. Epub 2015 Feb 16. PMID: 25698065.
- Thompson RH, Kurta JM, Kaag M, Tickoo SK, Kundu S, Katz D, Nogueira L, Reuter VE, Russo P. Tumor size is associated with malignant potential in renal cell carcinoma cases. J Urol. 2009 May;181(5):2033-6. doi: 10.1016/j.juro.2009.01.027. Epub 2009 Mar 14. PMID: 19286217; PMCID: PMC2734327.
- Perez-Ordonez B, Hamed G, Campbell S, Erlandson RA, Russo P, Gaudin PB, Reuter VE. Renal oncocytoma: a clinicopathologic study of 70 cases. Am J Surg Pathol. 1997 Aug;21(8):871-83. doi: 10.1097/00000478-199708000-00001. PMID: 9255250.
- Lane BR, Aydin H, Danforth TL, Zhou M, Remer EM, Novick AC, Campbell SC. Clinical correlates of renal angiomyolipoma subtypes in 209 patients: classic, fat poor, tuberous sclerosis associated and epithelioid. J Urol. 2008 Sep;180(3):836-43. doi: 10.1016/j.juro.2008.05.041. Epub 2008 Jul 16. PMID: 18635231.
- Kim JK, Park SY, Shon JH, Cho KS. Angiomyolipoma with minimal fat: differentiation from renal cell carcinoma at biphasic helical CT. Radiology. 2004 Mar;230(3):677-84. doi: 10.1148/radiol.2303030003. PMID: 14990834.
- Bhatt JR, Richard PO, Kim NS, Finelli A, Manickavachagam K, Legere L, Evans A, Pei Y, Sykes J, Jhaveri K, Jewett MAS. Natural History of Renal Angiomyolipoma (AML): Most Patients with Large AMLs >4cm Can Be Offered Active Surveillance as an Initial Management Strategy. Eur Urol. 2016 Jul;70(1):85-90. doi: 10.1016/j.eururo.2016.01.048. Epub 2016 Feb 9. PMID: 26873836.
- Yan J, Cheng JL, Li CF, Lian YB, Zheng Y, Zhang XP, Wang CY. The findings of CT and MRI in patients with metanephric adenoma. Diagn Pathol. 2016 Oct 27;11(1):104. doi: 10.1186/s13000-016-0535-x. PMID: 27784295; PMCID: PMC5081663.
- Davis CJ Jr, Barton JH, Sesterhenn IA, Mostofi FK. Metanephric adenoma. Clinicopathological study of fifty patients. Am J Surg Pathol. 1995 Oct;19(10):1101-14. doi: 10.1097/00000478-199510000-00001. PMID: 7573669.
- Patel U, Ramachandran N, Halls J, Parthipun A, Slide C. Synchronous renal masses in patients with a nonrenal malignancy: incidence of metastasis to the kidney versus primary renal neoplasia and differentiating features on CT. AJR Am J Roentgenol. 2011 Oct;197(4):W680-6. doi: 10.2214/AJR.11.6518. PMID: 21940540.
- Luciano RL, Brewster UC. Kidney involvement in leukemia and lymphoma. Adv Chronic Kidney Dis. 2014 Jan;21(1):27-35. doi: 10.1053/j.ackd.2013.07.004. PMID: 24359984.
- Park BK. Renal Angiomyolipoma: Radiologic Classification and Imaging Features According to the Amount of Fat. AJR Am J Roentgenol. 2017 Oct;209(4):826-835. doi: 10.2214/AJR.17.17973. Epub 2017 Jul 20. PMID: 28726505.
- Berland LL, Silverman SG, Gore RM, Mayo-Smith WW, Megibow AJ, Yee J, Brink JA, Baker ME, Federle MP, Foley WD, Francis IR, Herts BR, Israel GM, Krinsky G, Platt JF, Shuman WP, Taylor AJ. Managing incidental findings on abdominal CT: white paper of the ACR incidental findings committee. J Am Coll Radiol. 2010 Oct;7(10):754-73. doi: 10.1016/j.jacr.2010.06.013. PMID: 20889105.
- Newatia A, Khatri G, Friedman B, Hines J. Subtraction imaging: applications for nonvascular abdominal MRI. AJR Am J Roentgenol. 2007 Apr;188(4):1018-25. doi: 10.2214/AJR.05.2182. PMID: 17377038.
- Silverman SG, Pedrosa I, Ellis JH, Hindman NM, Schieda N, Smith AD, Remer EM, Shinagare AB, Curci NE, Raman SS, Wells SA, Kaffenberger SD, Wang ZJ, Chandarana H, Davenport MS. Bosniak Classification of Cystic Renal Masses, Version 2019: An Update Proposal and Needs Assessment. Radiology. 2019 Aug;292(2):475-488. doi: 10.1148/radiol.2019182646. Epub 2019 Jun 18. PMID: 31210616; PMCID: PMC6677285.
- Israel GM, Bosniak MA. An update of the Bosniak renal cyst classification system. Urology. 2005 Sep;66(3):484-8. doi: 10.1016/j.urology.2005.04.003. PMID: 16140062.
- Siegel CL, McFarland EG, Brink JA, Fisher AJ, Humphrey P, Heiken JP. CT of cystic renal masses: analysis of diagnostic performance and interobserver variation. AJR Am J Roentgenol. 1997 Sep;169(3):813-8. doi: 10.2214/ajr.169.3.9275902. PMID: 9275902.
- Bruner B, Breau RH, Lohse CM, Leibovich BC, Blute ML. Renal nephrometry score is associated with urine leak after partial nephrectomy. BJU Int. 2011 Jul;108(1):67-72. doi: 10.1111/j.1464-410X.2010.09837.x. Epub 2010 Nov 18. PMID: 21087391.
- Tobert CM, Kahnoski RJ, Thompson DE, Anema JG, Kuntzman RS, Lane BR. RENAL nephrometry score predicts surgery type independent of individual surgeon's use of nephron-sparing surgery. Urology. 2012 Jul;80(1):157-61. doi: 10.1016/j.urology.2012.03.025. Epub 2012 May 23. PMID: 22626579.
- Kutikov A, Uzzo RG. The R.E.N.A.L. nephrometry score: a comprehensive standardized system for quantitating renal tumor size, location and depth. J Urol. 2009 Sep;182(3):844-53. doi: 10.1016/j.juro.2009.05.035. Epub 2009 Jul 17. PMID: 19616235.
- Johnson CD, Dunnick NR, Cohan RH, Illescas FF. Renal adenocarcinoma: CT staging of 100 tumors. AJR Am J Roentgenol. 1987 Jan;148(1):59-63. doi: 10.2214/ajr.148.1.59. PMID: 3491524.
- Studer UE, Scherz S, Scheidegger J, Kraft R, Sonntag R, Ackermann D, Zingg EJ. Enlargement of regional lymph nodes in renal cell carcinoma is often not due to metastases. J Urol. 1990 Aug;144(2 Pt 1):243-5. doi: 10.1016/s0022-5347(17)39422-3. PMID: 2374186.
- Nayak JG, Patel P, Saarela O, Liu Z, Kapoor A, Finelli A, Tanguay S, Rendon R, Moore R, Black PC, Lacombe L, Breau RH, Kawakami J, Drachenberg DE. Pathological Upstaging of Clinical T1 to Pathological T3a Renal Cell Carcinoma: A Multi-institutional Analysis of Short-term Outcomes. Urology. 2016 Aug;94:154-60. doi: 10.1016/j.urology.2016.03.029. Epub 2016 Mar 31. PMID: 27041471.